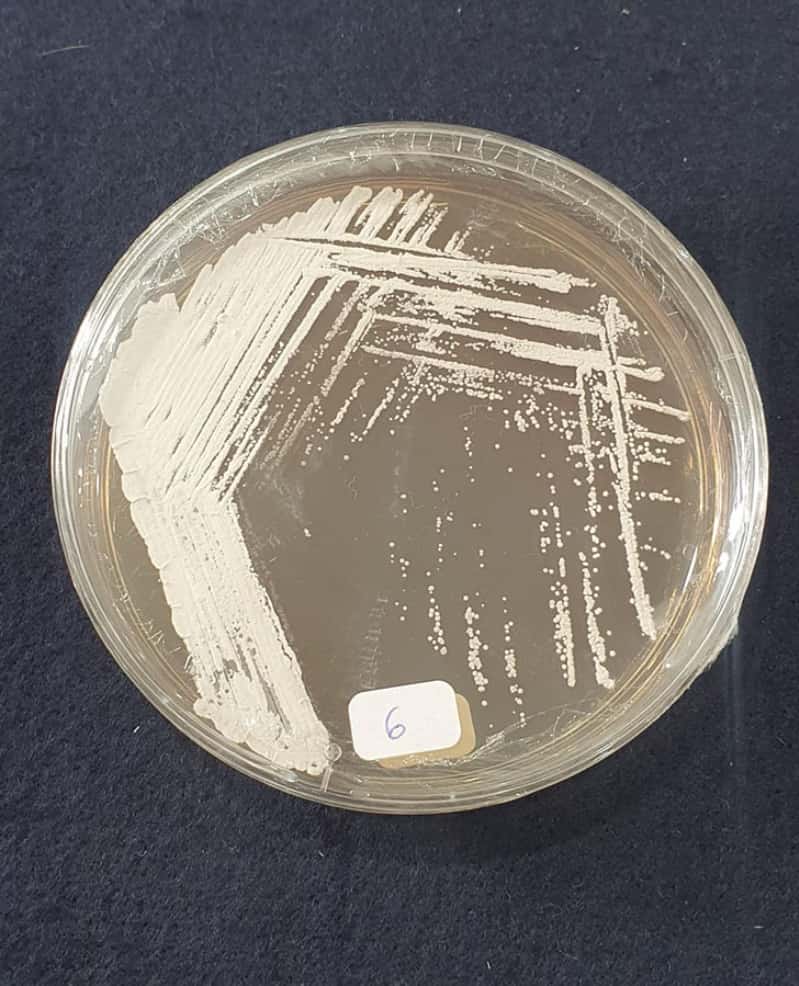
Bactéria da Caatinga abre caminho para bioherbicida eficaz contra a buva 2 Bactéria da caatinga

Pesquisadores brasileiros identificaram uma bactéria da caatinga capaz de inibir a germinação da buva (Conyza canadensis), uma das plantas daninhas mais difíceis de controlar no país.
A descoberta, resultado de um estudo conjunto da Embrapa Meio Ambiente e da Universidade de São Paulo (USP) em Ribeirão Preto, aponta para o desenvolvimento de um bioherbicida inovador e adaptado à realidade agrícola nacional.
Bactéria da caatinga capaz de inibir a germinação da buva
A pesquisa, publicada na revista Pest Management Science, foi conduzida pelo químico Osvaldo Ferreira, sob orientação dos pesquisadores Danilo Tosta Souza e Luiz Alberto Beraldo de Moraes, com a participação de Itamar Melo, da Embrapa.
O trabalho revelou que a bactéria Streptomyces sp. Caat 7-52, isolada em solos da Caatinga, produz moléculas naturais com efeito herbicida, incluindo o ácido 3-hidroxibenzóico e a albociclina.
A albociclina chamou atenção por apresentar, pela primeira vez, atividade fitotóxica contra a buva em baixas concentrações, tornando-se uma candidata promissora para o desenvolvimento de bioherbicidas.
A buva representa um grande desafio para a agricultura brasileira, presente em quase todas as regiões do país e resistente a diferentes herbicidas sintéticos. O controle inadequado da planta eleva custos, compromete a produtividade e aumenta os riscos ambientais ligados ao uso intenso de defensivos químicos.

Além da identificação dos compostos ativos, os cientistas exploraram técnicas de otimização do cultivo da bactéria, aumentando a produção de albociclina e de suas variantes.
Os testes com o caldo fermentado bruto também mostraram efeito seletivo contra dicotiledôneas, grupo que inclui diversas plantas daninhas, sem necessidade de purificação química. Segundo Beraldo, isso abre caminho para soluções mais simples, acessíveis e ambientalmente limpas para os agricultores.
Os próximos passos da pesquisa incluem experimentos em campo, avaliação da eficácia em diferentes culturas, desenvolvimento de formulações comerciais e estudos sobre impactos em organismos não alvo.
O objetivo é integrar a tecnologia a programas de Manejo Integrado de Plantas Daninhas (MIPD), equilibrando produtividade e sustentabilidade.







